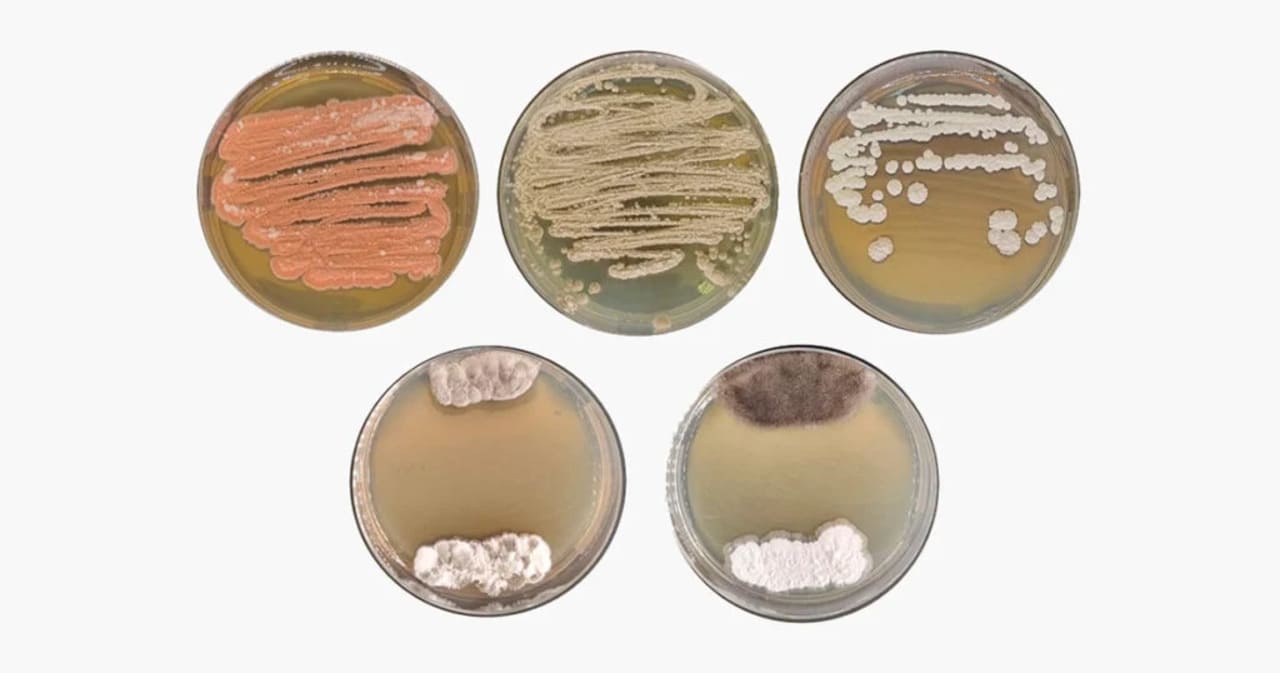

Paraná lança Banco Verde para impulsionar a economia ecológica
O Paraná acaba de inaugurar uma iniciativa que promete transformar a relação entre o setor privado e os projetos ambientais de impacto social. Batizada de Banco... Leia mais.

Brasil inaugura usina pioneira de etanol de trigo no Rio Grande do Sul
Na cidade de Santiago, localizada no coração do Rio Grande do Sul, um novo capítulo da produção de energia renovável começou a ser escrito. Com uma proposta... Leia mais.

Carne bovina dispara nos EUA com rebanho em queda e pressão tarifária
A carne bovina tem se tornado um item de luxo para muitos consumidores norte-americanos. O aumento dos preços, que já vinha sendo sentido ao longo de 2025, é... Leia mais.

Nova sucuri da Amazônia pode chegar a 200 kg e muda o que sabemos sobre predadores gigantes
Entre águas escuras e margens alagadas da floresta amazônica, um dos maiores predadores do continente sul-americano acaba de ganhar um novo nome. A sucuri-verde,... Leia mais.

Salário médio da agropecuária no Paraná surpreende e ultrapassa em 58% a média nacional
A agropecuária paranaense vive um momento de alta não apenas nas lavouras, mas também no bolso de quem trabalha nelas. No segundo trimestre de 2025, o Paraná... Leia mais.

Tarifa dos EUA ameaça exportações brasileiras de tilápia no segundo semestre
O primeiro semestre de 2025 foi promissor para a exportação de tilápia brasileira: com crescimento expressivo de 52% no volume embarcado em relação ao mesmo... Leia mais.

Curso gratuito ensina técnicas para o cultivo do feijão-caupi
O feijão-caupi, também conhecido como feijão-de-corda, tem se consolidado como uma alternativa altamente produtiva e adaptável em diversas regiões do Brasil,... Leia mais.
Microrganismos da Amazônia podem revolucionar agricultura e farmacologia
Poucos ambientes do planeta reúnem uma riqueza biológica tão vasta e ainda pouco explorada como a Floresta Amazônica. Esse imenso patrimônio natural, além... Leia mais.

Kakapo: o papagaio que não voa e quase sumiu do mapa
Por muito tempo, o kakapo foi presença constante nos ambientes da Nova Zelândia, onde reinava como o papagaio mais abundante do arquipélago. Reconhecido por sua... Leia mais.

Brasil se une a EUA e Austrália para reposicionar o algodão no mercado
Num cenário em que a competitividade global exige diferenciais não apenas econômicos, mas também ambientais e sociais, o algodão natural produzido por Brasil,... Leia mais.